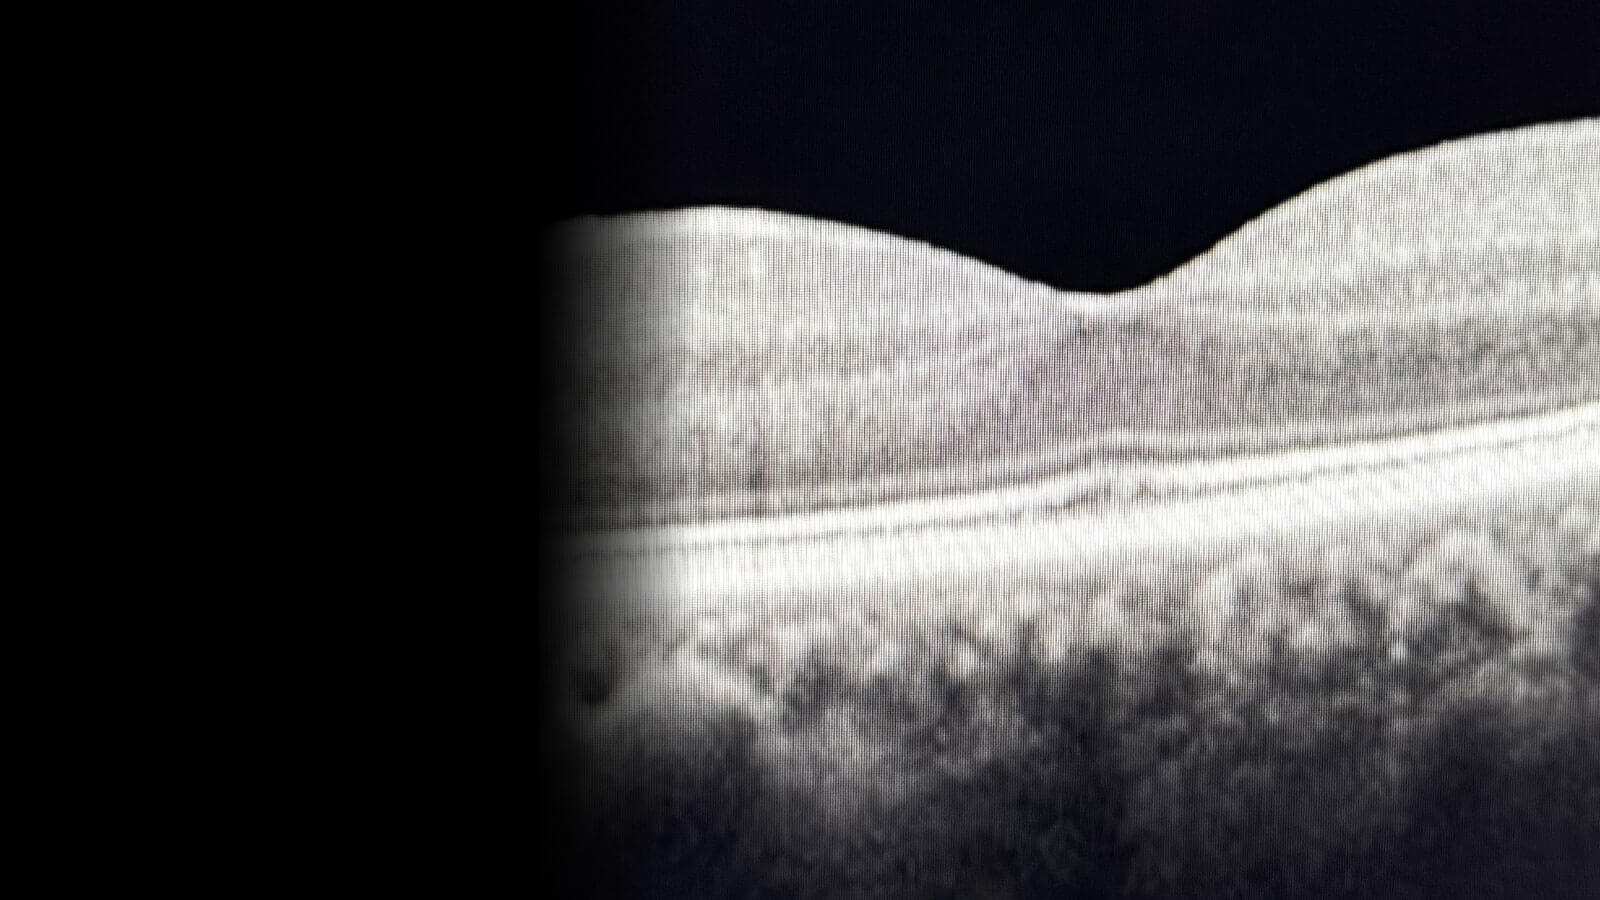
retina scan

Comprehensive Retinal Imaging Expertise
Established in 1999, the Retina Diseases Image Analysis Reading Center (REDIARC) specializes in comprehensive evaluation of retinal and vitreoretinal diseases through the analysis of advanced imaging modalities.
Contact Us Today
Call: 216-844-3615
Email: EIARC@UHhospitals.org
or fill out our online form.
Areas of Expertise
The Retina Diseases Image Analysis Reading Center's (REDIARC) experienced team of ophthalmologists, optometrists, and certified graders provides consistent, high-fidelity image interpretation for prospective clinical trials and translational research. The center’s expertise spans diabetic retinopathy, macular degeneration, uveitis, and other retinal disorders. Using multi-modal imaging including:
- Fundus photography
- Fluorescein angiography
- Autofluorescence
- Optical coherence tomography,
The REDIARC delivers precise and reproducible grading for large-scale national and international studies. In addition to ophthalmic research, the REDIARC supports non-ophthalmologic clinical trials, providing ocular safety assessments for systemic drugs and devices.
Through the integration of multiple imaging technologies, standardized grading methodologies, and rigorous data validation, the REDIARC ensures that every data set meets regulatory and scientific publication requirements. This commitment to quality and innovation continues to advance the field of retinal imaging and support breakthroughs in ophthalmic care.


